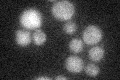
YGR144W

View description
Thiazole synthase, catalyzes formation of a thiazole intermediate during thiamine biosynthesis; required for mitochondrial genome stability in response to DNA damaging agents
Localization:
Intensity:
Fold change:
Significance:
-
C’ GFP library in SD
below threshold17.11 -
N' NOP1pr-GFP in SD

cytosol330.576 -
N' TEF2pr-mCherry in SD

cytosol404.688 -
N' NATIVEpr-GFP in SD

below threshold19.5661 -
N' TEF2pr-VC and Cyto-VN in SD

cytosol81.6842 -
C’ GFP library in SD+DTT

cytosol19.021.11No -
C’ GFP library in SD+H2O2

cytosol17.030.99No -
C’ GFP library in Starvation Media

cytosol17.831.04No -
C’ GFP library on the background of Pup2-DaMP

below threshold -
C’ GFP library on the background of CCT mutant

below threshold17.11571No
